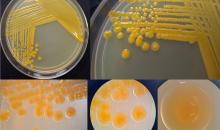

Curtobacterium poinsettiae(CORBPO)
Overview
Code created in: 2002-03-11
Basic information
- EPPO Code:
CORBPO
- Preferred name:
Curtobacterium poinsettiae
- Authority:
(Starr and Pirone) Osdaghi et al.
Other scientific names
| Name |
Authority |
| Bacterium poinsettiae |
(Starr & Pirone) Hauduroy et al. |
| Corynebacterium flaccumfaciens pv. poinsettiae |
(Starr & Pirone) Dye & Kemp |
| Corynebacterium poinsettiae |
(Starr & Pirone) Burkholder |
| Curtobacterium flaccumfaciens pv. poinsettiae |
(Starr & Pirone) Collins & Jones |
| Phytomonas poinsettiae |
Starr & Pirone |
Common names
| Name |
Language |
| leaf spot of poinsettia |
English |
| stem canker of poinsettia |
English |
| chancre de la tige du poinsettia |
French |
| chancro del tallo de la poinsetia |
Spanish |